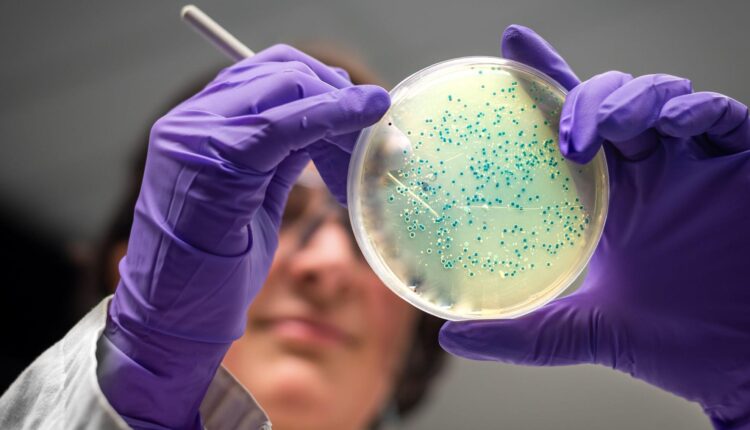

Des chercheurs ont révélé que l’intelligence artificielle a inventé deux nouveaux antibiotiques potentiels qui pourraient tuer la gonorrhée et le SARM résistants aux médicaments.
Les médicaments ont été conçus atome par atome par l’IA et ont tué les superbactéries lors de tests en laboratoire et sur des animaux.
Les deux composés nécessitent encore des années de perfectionnement et d’essais cliniques avant de pouvoir être prescrits.
Mais l’équipe du Massachusetts Institute of Technology estime que l’IA pourrait marquer le début d’un « deuxième âge d’or » dans la découverte d’antibiotiques.
Les antibiotiques tuent les bactéries, mais les infections qui résistent au traitement causent aujourd’hui plus d’un million de décès par an.
La surconsommation d’antibiotiques a permis aux bactéries d’évoluer pour éviter les effets des médicaments et il y a une pénurie de nouveaux antibiotiques depuis des décennies.
Des chercheurs ont déjà utilisé l’IA pour passer au crible des milliers de produits chimiques connus afin d’identifier ceux qui pourraient devenir de nouveaux antibiotiques.
Aujourd’hui, l’équipe du MIT est allée plus loin en utilisant l’IA générative pour concevoir des antibiotiques.
Leur étude, publiée dans la revue Cell, a porté sur 36 millions de composés, y compris ceux qui n’existent pas ou qui n’ont pas encore été découverts.
Les scientifiques ont formé l’IA en lui donnant la structure chimique de composés connus ainsi que des données indiquant s’ils ralentissent la croissance de différentes espèces de bactéries.
L’IA apprend ensuite comment les bactéries sont affectées par différentes structures moléculaires, constituées d’atomes tels que le carbone, l’oxygène, l’hydrogène et l’azote.
Deux approches ont ensuite été testées pour concevoir de nouveaux antibiotiques à l’aide de l’IA. La première a permis d’identifier un point de départ prometteur en recherchant dans une bibliothèque de millions de fragments chimiques, d’une taille de 8 à 19 atomes, et de construire à partir de là. La seconde a donné à l’IA les coudées franches dès le départ.
Le processus de conception a également permis d’éliminer tout ce qui ressemblait trop aux antibiotiques actuels, de s’assurer qu’il s’agissait bien d’inventer des médicaments plutôt que des savons et de filtrer tout ce qui risquait d’être toxique pour l’homme.
Les scientifiques ont utilisé l’IA pour créer des antibiotiques contre l’infection sexuellement transmissible de la gonorrhée et contre le SARM (Staphylococcus aureus résistant à la méthicilline), un type de bactérie qui vit inoffensivement sur la peau mais qui peut provoquer une infection grave si elle pénètre dans l’organisme.
Une fois fabriqués, les meilleurs modèles ont été testés sur des bactéries en laboratoire et sur des souris infectées, ce qui a donné naissance à deux nouveaux médicaments potentiels.
« Nous sommes ravis car nous montrons que l’IA générative peut être utilisée pour concevoir des antibiotiques totalement nouveaux », explique le professeur James Collins, du MIT, à la BBC.
« L’IA peut nous permettre de créer des molécules rapidement et à peu de frais et, ainsi, d’élargir notre arsenal et de nous donner une longueur d’avance dans la bataille que nous livrons contre les gènes des superbactéries ».
Toutefois, ces médicaments ne sont pas prêts pour les essais cliniques et devront être affinés – ce qui nécessitera encore un à deux ans de travail – avant que ne commence le long processus d’expérimentation sur l’homme.
Le Dr Andrew Edwards, de l’initiative Fleming et de l’Imperial College London, a déclaré que ces travaux sont « très importants » et présentent un « potentiel énorme », car ils « démontrent une nouvelle approche pour l’identification de nouveaux antibiotiques ».
Mais il a ajouté : « Si l’IA promet d’améliorer considérablement la découverte et le développement de médicaments, nous devons encore faire le gros du travail lorsqu’il s’agit de tester la sécurité et l’efficacité ».
Ce processus peut être long et coûteux, sans garantie que les médicaments expérimentaux seront prescrits aux patients à la fin.
Certains appellent à l’amélioration de la découverte de médicaments par l’IA de manière plus générale. Le professeur Collins estime que « nous avons besoin de meilleurs modèles », qui ne se limitent pas à l’efficacité des médicaments en laboratoire, mais qui permettent de mieux prédire leur efficacité dans l’organisme.
La difficulté de fabrication des produits conçus par l’IA pose également problème. Sur les 80 premiers traitements théoriques de la gonorrhée, seuls deux ont été synthétisés pour créer des médicaments.
Le professeur Chris Dowson, de l’université de Warwick, a déclaré que l’étude était « cool » et qu’elle montrait que l’IA constitue « une avancée significative en tant qu’outil de découverte d’antibiotiques permettant d’atténuer l’émergence de la résistance ».
Toutefois, explique-t-il, les infections résistantes aux médicaments posent également un problème économique : « comment fabriquer des médicaments qui n’ont aucune valeur commerciale ? »
Si un nouvel antibiotique était inventé, l’idéal serait de l’utiliser le moins possible pour préserver son efficacité, ce qui rendrait difficile la réalisation d’un profit.
- L’IA résout en deux jours le problème des superbactéries qui a pris des années aux scientifiques
- La recherche fascinante sur le cerveau d’une mouche qui fera la lumière sur le processus de pensée humaine
- L’intelligence artificielle peut-elle vous aider à vous mettre en forme ?
Source:news.abidjan.net